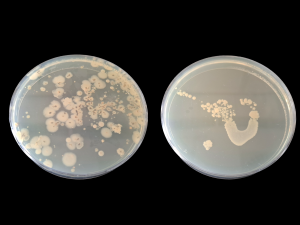

Dortmund, 9. April 2025
Wie entsteht eigentlich eine Entzündung? Und wie lassen sich Erreger wie Viren oder Bakterien identifizieren? Beim Girls‘ Day 2025 am ISAS konnten zwölf Schülerinnen genau das herausfinden. Einen Schultag lang haben die 13- bis 14- jährigen Mädchen die Arbeit der Forscherinnen und Technischen Assistentinnen am Institut kennengelernt. Unter dem Motto „Bakterien & Bonbons – Was verrät unsere Atemluft?“ haben sie Bakterien aus der Umgebung gesammelt und kultiviert, sowie Einblicke in die Headspace- und Atemluftmessung mit dem Ionenmobilitätsspektrometer (IMS) (s. Infobox) erhalten.
Auf der Jagd nach Bakterien
Der Tag startete für die jungen Besucherinnen mit einer kleinen Einführung in das Thema Entzündungen: Wie es dazu kommt, man diese erkennt und auch wie man sie bekämpft. Im Anschluss begaben sich die Schülerinnen auf eine gemeinsame Jagd nach Bakterien aus der Umgebung. Mit Agarplatten ausgerüstet machten sie sich auf zu den Küchenschwämmen und Pflanzen des Instituts. Selbst aus der Luft holten sie sich Bakterien. Dann nur noch Deckel drauf und beschriften – schon war die Jagd für die Schülerinnen beendet. Für die eingesammelten Bakterien ging es hingegen in den Wärmeschrank: Bei lauschigen 37°C konnten sie sich fröhlich vermehren.
Bakterien und veganer Wackelpudding
Im Anschluss ging es für die Nachwuchsforscherinnen direkt ins Labor. Begleitet von Prisca Weider, Doktorandin, und Lisa Chmielewski, Technische Assistentin, arbeiteten die Mädchen in je zwei Gruppen abwechselnd an der Herstellung von Bakterienkulturen und der Analyse von Atemluft.
Auch beim Girls‘ Day gelten im Labor dabei einige Grundregeln: Kittel und Handschuhe anziehen! Weiter ging es mit der Einführung in das erste Experiment: Wie gieße ich eine Agarplatte? Warum ist die Substanz aus Algen ein idealer Nährboden für Bakterien? Wie unterscheidet sich das pflanzliche Geliermittel von veganem Wackelpudding? Unter der Leitung von Dr. Christina Sengstock lernten die Teilnehmerinnen, wie man mit den Agarplatten arbeitet. Die erste Aufgabe: Abklatschproben mit jeweils ungewaschenen, gewaschenen und desinfizierten Händen anzufertigen. Nach dem High five mit der Agarplatte lernten die Nachwuchsforscherinnen die Wirkung von Silberacetat auf Escherichia coli kennen. Für die Experimente brauchten sie eine sterile Umgebung. Und die erreichen sie mit Feuer. Also standen die Mädchen mit Pipetten ausgerüstet um drei entzündeten Bunsenbrenner herum und begannen mit dem Ausplattieren. Für Sengstock war der Girls‘ Day eine Abwechslung: „Ich finde es erfrischend, junge Leute zu treffen und zu erfahren, was so ihre Interessen sind. Es ist schön zu wissen, dass immer noch Interesse für unsere Berufsrichtung besteht. Man fragt sich dann ja auch immer: Können wir es schaffen, junge Leute für die Wissenschaft zu begeistern?“

Dr. Christina Sengstock erklärt den Schülerinnen das Ausplattieren. Mia (14, links) und Helene (13, rechts) hören aufmerksam zu.
© ISAS
Bonbons für die Forschung
Eine Etage weiter unten verteilten die Doktorandinnen Annika Fechner und Luisa Speicher währenddessen Bonbons an ihre Gruppe. „Wenn man den Schülerinnen im Labor etwas zeigen möchte, muss man sich natürlich vorher überlegen, wie man es erklärt. Sachen, die für uns zum Alltag gehören, müssen für sie nicht genauso verständlich sein.“, so Fechner. Für ihr Experiment führte sie mit den Mädchen Atemluftmessungen am IMS durch. Die in der Atemluft enthaltenden flüchtigen organischen Substanzen (volatile organic compounds, VOCs) können der Früherkennung von Krankheiten, wie etwa einer Lungenentzündung dienen. Zur Demonstration benutzte Fechner verschiedene Bonbons. Das IMS analysierte die Duftstoffe im Kirsch- oder Minz-Atem der Teilnehmerinnen. Die Duftstoffe wirkten als „Platzhalter“ für die VOCs, die bei Krankheiten entstehen. Für eine Headspace-Messung stellten die Teilnehmerinnen zusätzlich Bonbonlösungen her. Anhand der Gase, die aus der Probe austreten, konnten sie die Bestandteile Probe analysieren. Nach einer Mittagspause und anschließender Auswertung der Experimente endete der Tag für die Besucherinnen.

Doktorandin Annika Fechner reicht Helene (13) das Mundstück für die Atemluftmessung am Ionenmobilitätsspektrometer.
© ISAS
Headspace- & Atemluftmessung mit dem IMS
Das Ionenmobilitätspektrometer (IMS) ionisiert Substanzen in einer Probe und trennt diese anschließend in einem elektrischen Feld basierend auf der Driftgeschwindigkeit. Diese hängt von Größe, Masse und Ladung der Ionen ab. Auf diese Weise können spezifische Substanzen identifiziert werden. Bei einer Atemluftmessung kann das IMS so die einzelnen Bestandteile der ausgeatmeten Luft bestimmen. Die Headspace- oder auch Dampfraumanalyse konzentriert sich hingegen auf die flüchtigen Bestandteile oberhalb einer festen oder flüssigen Probe. Die Gase, die aus der Probe entweichen – etwa bei einem zerkleinerten Bonbon – lassen sich mit dem IMS gezielt auf ihre chemischen Bestandteile untersuchen.

Auch Helene (13) hat ein Bonbon erhalten und lässt ihren Atem vom Ionenmobilitätsspektrometer analysieren. Jetzt heißt es: Pusten!
© ISAS

Für die Headspace-Messung müssen die Nachwuchsforscherinnen die Bonbon-Proben zunächst aufbereiten. Doktorandin Luisa Speicher erklärt Helene (13), Emma (14) und Helene (13) (von vorne nach hinten), wie sie die Proben mit dem Vortexmischer kräftig durchschütteln.
© ISAS
Nach 24 Stunden im Inkubator wird die Ausbeute der Bakterienjagd mit bloßem Auge sichtbar: Die Bakterien aus der Blumenerde (links) und einem Spülschwamm (rechts) haben sich sichtbar vermehrt.
Die Koordination des Girls‘ Day 2025 am ISAS hat das Team Kommunikation mit tatkräftiger Unterstützung von zwei studentischen Praktikantinnen übernommen. Anna Becker hat den Tag für die jungen Teilnehmerinnen geplant und bei der Durchführung geholfen. Lena Kantert hat sie dabei unterstützt. Beide studieren Wissenschaftsjournalismus an der Technischen Universität Dortmund.
(Lena Kantert)








